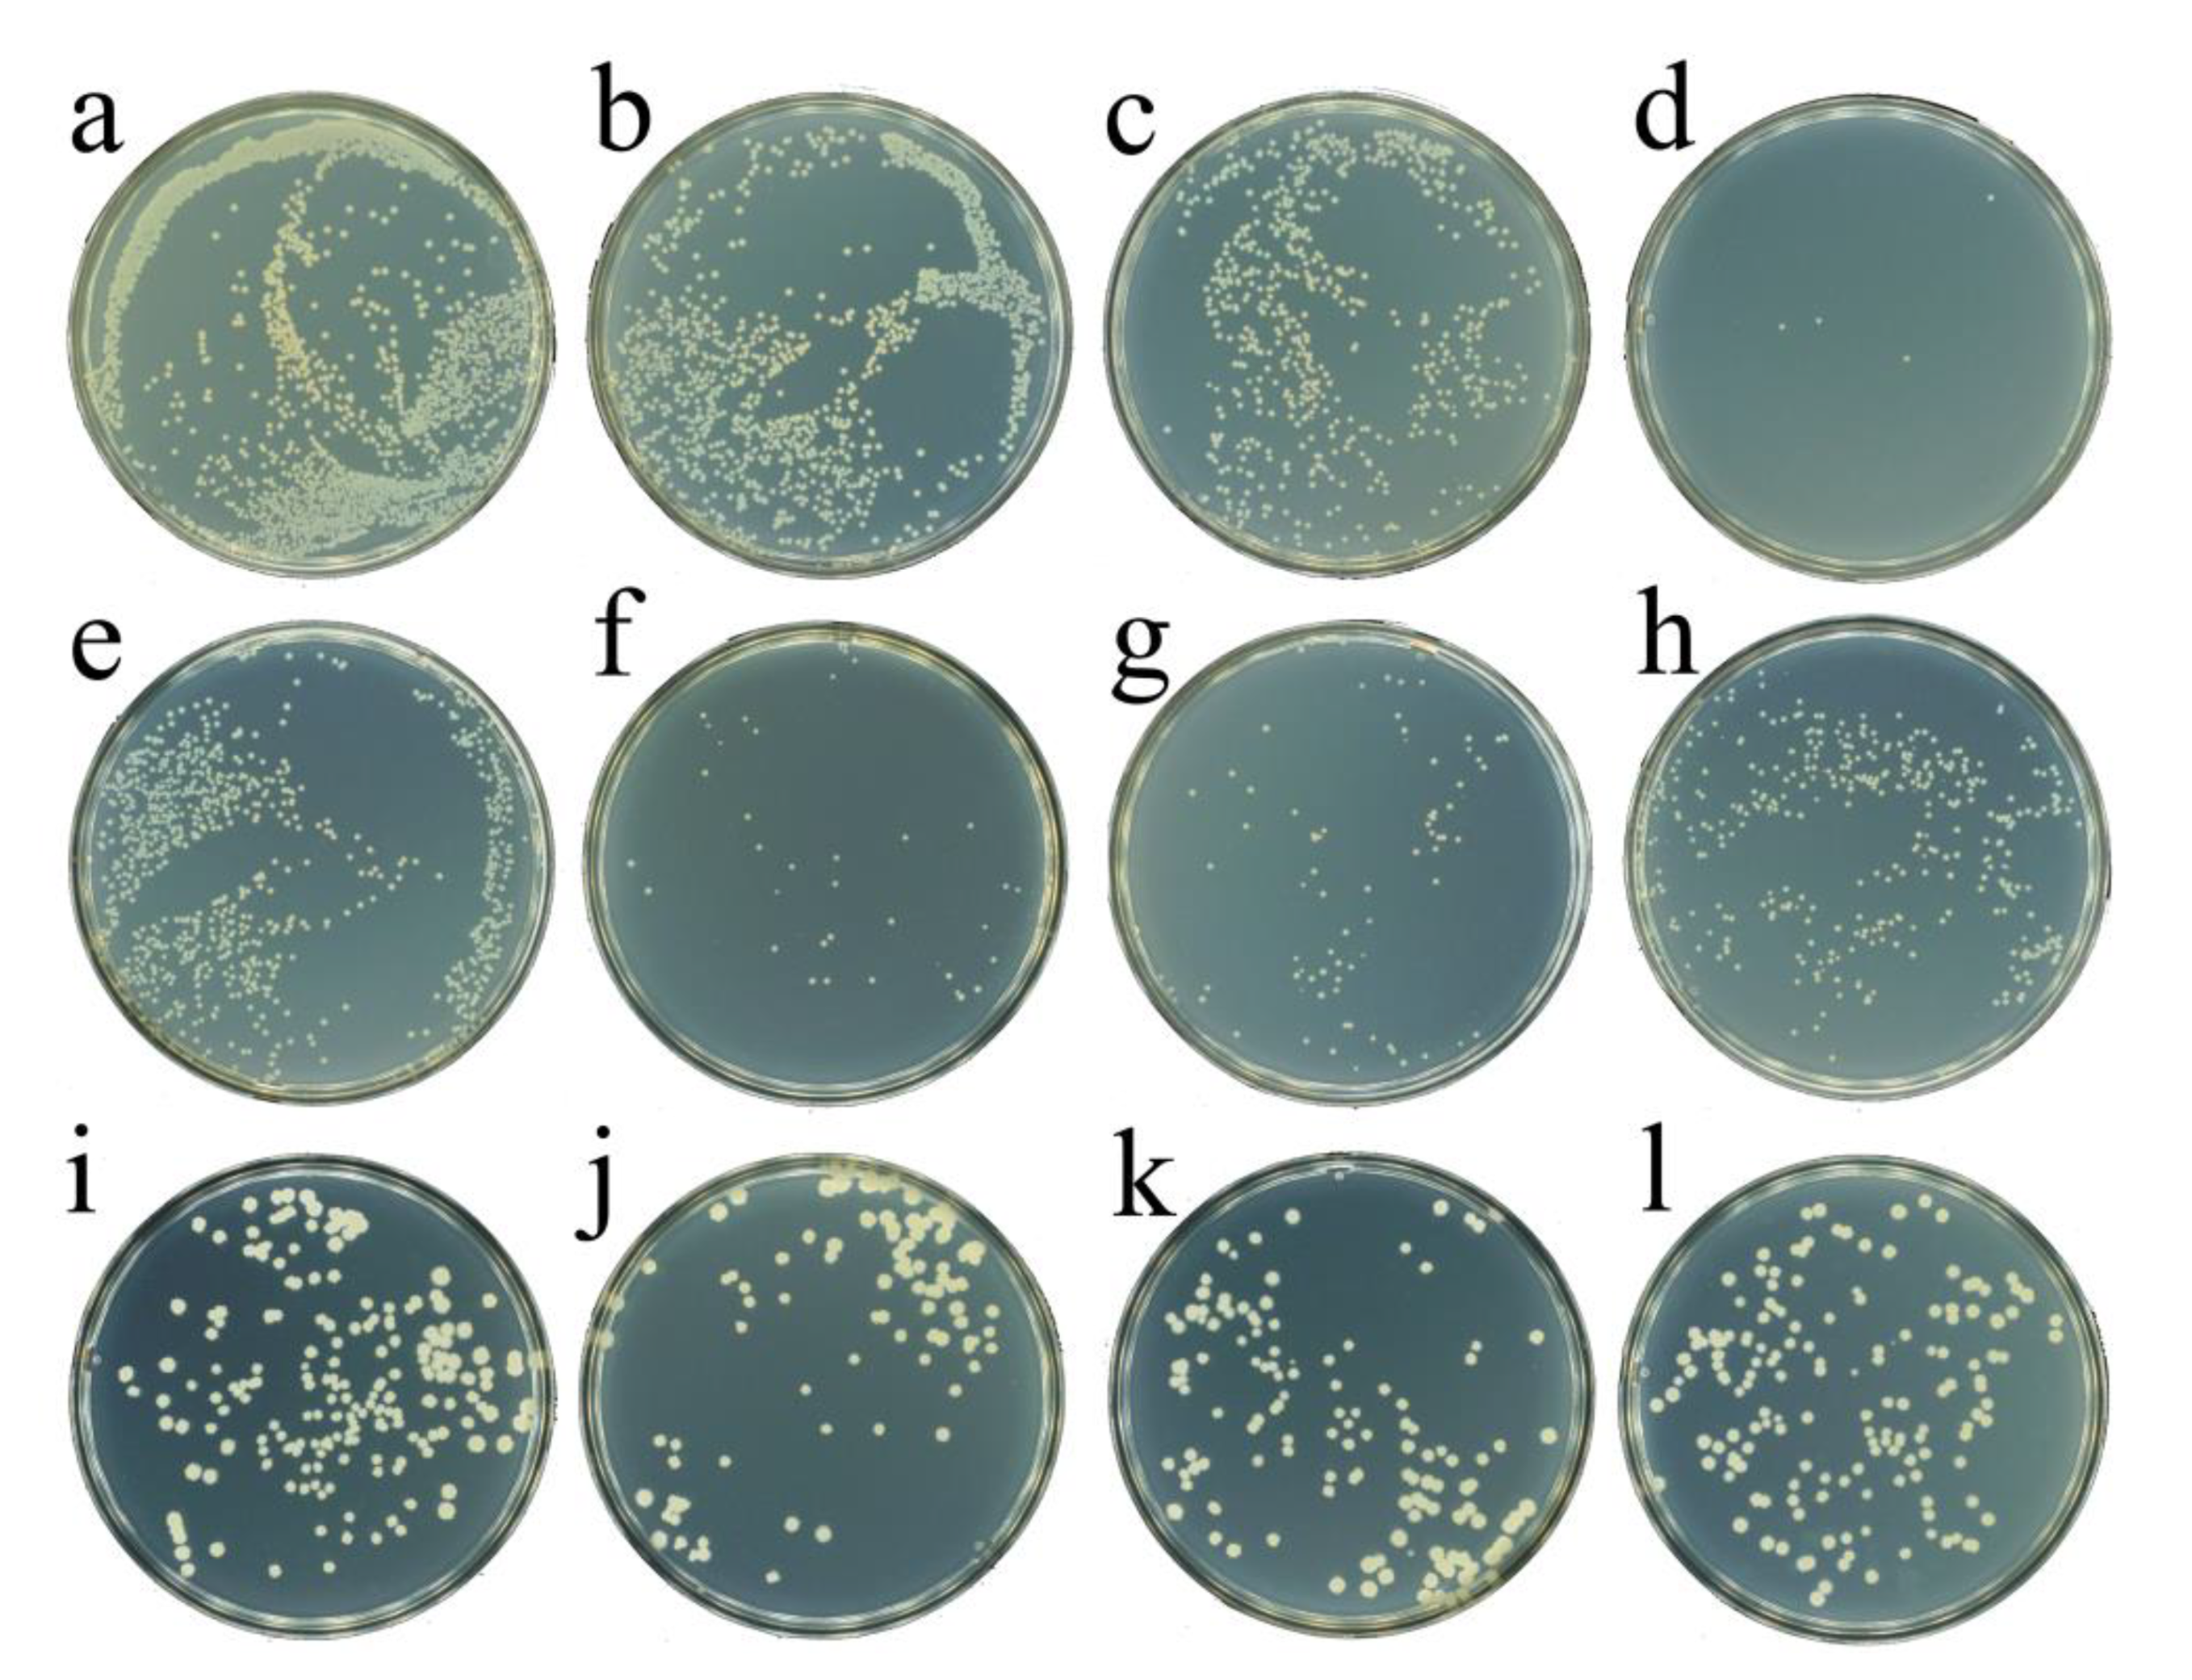
Molecules 26 03747 g004

Will the Bacteria Survive in the CeO2 Nanozyme-H2O2 System?
Abstract
:1. Introduction
2. Results
2.1. Preparation and Characterization of CeO2 Nanozyme
2.2. The Peroxidase Activity of CeO2 Nanozyme
2.3. ROS Generation
2.4. The Evaluation of Antibacterial Activity of CeO2-H2O2 System
3. Materials and Methods
3.1. Chemicals and Instrument
3.2. Synthesis of CeO2 Nanozyme
3.3. Detection of Peroxidase Activity of CeO2
3.4. Detection of OH
3.5. Antibacterial Experiment
4. Conclusions
Author Contributions
Funding
Institutional Review Board Statement
Informed Consent Statement
Data Availability Statement
Conflicts of Interest
Sample Availability
References
- Chen, Z.; Wang, Z.; Ren, J.; Qu, X. Enzyme Mimicry for Combating Bacteria and Biofilms. Acc. Chem. Res. 2018, 51, 789–799. [Google Scholar] [CrossRef]
- Lin, Y.; Ren, J.; Qu, X. Nano-Gold as Artificial Enzymes: Hidden Talents. Adv. Mater. 2014, 26, 4200–4217. [Google Scholar] [CrossRef] [PubMed]
- Wu, J.; Wang, X.; Wang, Q.; Lou, Z.; Li, S.; Zhu, Y.; Qin, L.; Wei, H. Nanomaterials with enzyme-like characteristics (nanozymes): Next-generation artificial enzymes (II). Chem. Soc. Rev. 2019, 48, 1004–1076. [Google Scholar] [CrossRef]
- Huang, Y.; Su, E.; Ren, J.; Qu, X. The recent biological applications of selenium-based nanomaterials. Nano Today 2021, 38, 101205. [Google Scholar] [CrossRef]
- Jiang, D.; Ni, D.; Rosenkrans, Z.T.; Huang, P.; Yan, X.; Cai, W. Nanozyme: New horizons for responsive biomedical applications. Chem. Soc. Rev. 2019, 48, 3683–3704. [Google Scholar] [CrossRef] [PubMed]
- Meng, X.; Zare, I.; Yan, X.; Fan, K. Protein-protected metal nanoclusters: An emerging ultra-small nanozyme. WIREs Nanomed. Nanobiotechnol. 2020, 12, e1602. [Google Scholar] [CrossRef]
- Sun, H.; Zhou, Y.; Ren, J.; Qu, X. Carbon Nanozymes: Enzymatic Properties, Catalytic Mechanism, and Applications. Angew. Chem. Int. Ed. 2018, 57, 9224–9237. [Google Scholar] [CrossRef] [PubMed]
- Huang, Y.; Ren, J.; Qu, X. Nanozymes: Classification, Catalytic Mechanisms, Activity Regulation, and Applications. Chem. Rev. 2019, 119, 4357–4412. [Google Scholar] [CrossRef] [PubMed]
- Wang, Q.; Wei, H.; Zhang, Z.; Wang, E.; Dong, S. Nanozyme: An emerging alternative to natural enzyme for biosensing and immunoassay. TrAC Trends Anal. Chem. 2018, 105, 218–224. [Google Scholar] [CrossRef]
- Dong, H.; Fan, Y.; Zhang, W.; Gu, N.; Zhang, Y. Catalytic Mechanisms of Nanozymes and Their Applications in Biomedicine. Bioconjugate Chem. 2019, 30, 1273–1296. [Google Scholar] [CrossRef]
- Wang, H.; Wan, K.; Shi, X. Recent Advances in Nanozyme Research. Adv. Mater. 2019, 31, 1805368. [Google Scholar] [CrossRef]
- Wang, Z.; Zhang, Y.; Ju, E.; Liu, Z.; Cao, F.; Chen, Z.; Ren, J.; Qu, X. Biomimetic nanoflowers by self-assembly of nanozymes to induce intracellular oxidative damage against hypoxic tumors. Nat. Commun. 2018, 9, 3334. [Google Scholar] [CrossRef] [PubMed]
- Chen, Z.; Ji, H.; Liu, C.; Bing, W.; Wang, Z.; Qu, X. A Multinuclear Metal Complex Based DNase-Mimetic Artificial Enzyme: Matrix Cleavage for Combating Bacterial Biofilms. Angew. Chem. Int. Ed. 2016, 55, 10732–10736. [Google Scholar] [CrossRef]
- Han, Q.; Lau, J.W.; Do, T.C.; Zhang, Z.; Xing, B. Near-Infrared Light Brightens Bacterial Disinfection: Recent Progress and Perspectives. ACS Appl. Bio Mater. 2020, 4, 3937–3961. [Google Scholar] [CrossRef]
- Liu, Y.; Shi, L.; Su, L.; van der Mei, H.C.; Jutte, P.C.; Ren, Y.; Busscher, H.J. Nanotechnology-based antimicrobials and delivery systems for biofilm-infection control. Chem. Soc. Rev. 2019, 48, 428–446. [Google Scholar] [CrossRef] [PubMed]
- Zhang, Z.; Han, Q.; Lau, J.W.; Xing, B. Lanthanide-Doped Upconversion Nanoparticles Meet the Needs for Cutting-Edge Bioapplications: Recent Progress and Perspectives. ACS Mater. Lett. 2020, 2, 1516–1531. [Google Scholar] [CrossRef]
- Cao, F.; Zhang, L.; Wang, H.; You, Y.; Wang, Y.; Gao, N.; Ren, J.; Qu, X. Defect-Rich Adhesive Nanozymes as Efficient Antibiotics for Enhanced Bacterial Inhibition. Angew. Chem. Int. Ed. 2019, 58, 16236–16242. [Google Scholar] [CrossRef]
- Gao, F.; Shao, T.; Yu, Y.; Xiong, Y.; Yang, L. Surface-bound reactive oxygen species generating nanozymes for selective antibacterial action. Nat. Commun. 2021, 12. [Google Scholar] [CrossRef] [PubMed]
- He, X.; Tian, F.; Chang, J.; Bai, X.; Yuan, C.; Wang, C.; Neville, A. Haloperoxidase Mimicry by CeO2-x Nanorods of Different Aspect Ratios for Antibacterial Performance. ACS Sustain. Chem. Eng. 2020, 8, 6744–6752. [Google Scholar] [CrossRef]
- Hu, M.; Korschelt, K.; Viel, M.; Wiesmann, N.; Kappl, M.; Brieger, J.; Landfester, K.; Therien-Aubin, H.; Tremel, W. Nanozymes in Nanofibrous Mats with Haloperoxidase-like Activity to Combat Biofouling. ACS Appl. Mater. Interfaces 2018, 10, 44722–44730. [Google Scholar] [CrossRef] [PubMed]
- Liu, X.; Yan, Z.; Zhang, Y.; Liu, Z.; Sun, Y.; Ren, J.; Qu, X. Two-Dimensional Metal-Organic Framework/Enzyme Hybrid Nanocatalyst as a Benign and m Self-Activated Cascade Reagent for in Vivo Wound Healing. ACS Nano 2019, 13, 5222–5230. [Google Scholar] [CrossRef]
- Liu, Z.; Zhao, X.; Yu, B.; Zhao, N.; Zhang, C.; Xu, F.-J. Rough Carbon-Iron Oxide Nanohybrids for Near-Infrared-II Light-Responsive Synergistic Antibacterial Therapy. ACS Nano 2021, 15, 7482–7490. [Google Scholar] [CrossRef]
- Wu, R.; Chong, Y.; Fang, G.; Jiang, X.; Pan, Y.; Chen, C.; Yin, J.-J.; Ge, C. Synthesis of Pt Hollow Nanodendrites with Enhanced Peroxidase-Like Activity against Bacterial Infections: Implication for Wound Healing. Adv. Funct. Mater. 2018, 28. [Google Scholar] [CrossRef]
- Xu, B.; Wang, H.; Wang, W.; Gao, L.; Li, S.; Pan, X.; Wang, H.; Yang, H.; Meng, X.; Wu, Q.; et al. A Single-Atom Nanozyme for Wound Disinfection Applications. Angew. Chem. Int. Ed. 2019, 58, 4911–4916. [Google Scholar] [CrossRef]
- Sun, H.; Gao, N.; Dong, K.; Ren, J.; Qu, X. Graphene Quantum Dots-Band-Aids Used for Wound Disinfection. ACS Nano 2014, 8, 6202–6210. [Google Scholar] [CrossRef] [PubMed]
- Shan, J.; Li, X.; Yang, K.; Xiu, W.; Wen, Q.; Zhang, Y.; Yuwen, L.; Weng, L.; Teng, Z.; Wang, L. Efficient Bacteria Killing by Cu2WS4 Nanocrystals with Enzyme-like Properties and Bacteria-Binding Ability. ACS Nano 2019, 13, 13797–13808. [Google Scholar] [CrossRef]
- Liang, X.; Xiao, J.; Chen, B.; Li, Y. Catalytically Stable and Active CeO2 Mesoporous Spheres. Inorg. Chem. 2010, 49, 8188–8190. [Google Scholar] [CrossRef] [PubMed]
- Wang, L.; Gao, F.; Wang, A.; Chen, X.; Li, H.; Zhang, X.; Zheng, H.; Ji, R.; Li, B.; Yu, X.; et al. Defect-Rich Adhesive Molybdenum Disulfide/rGO Vertical Heterostructures with Enhanced Nanozyme Activity for Smart Bacterial Killing Application. Adv. Mater. 2020, 32, 2005423. [Google Scholar] [CrossRef] [PubMed]
- Yang, Y.; Wu, X.; Ma, L.; He, C.; Cao, S.; Long, Y.; Huang, J.; Rodriguez, R.D.; Cheng, C.; Zhao, C.; et al. Bioinspired Spiky Peroxidase-Mimics for Localized Bacterial Capture and Synergistic Catalytic Sterilization. Adv. Mater. 2021, 33, 2005477. [Google Scholar] [CrossRef]
- Yim, G.; Kim, C.Y.; Kang, S.; Min, D.-H.; Kang, K.; Jang, H. Intrinsic Peroxidase-Mimicking Ir Nanoplates for Nanozymatic Anticancer and Antibacterial Treatment. ACS Appl. Mater. Interfaces 2020, 12, 41062–41070. [Google Scholar] [CrossRef] [PubMed]
- Yu, Z.-H.; Li, X.; Xu, F.; Hu, X.-L.; Yan, J.; Kwon, N.; Chen, G.-R.; Tang, T.; Dong, X.; Mai, Y.; et al. A Supramolecular-Based Dual-Wavelength Phototherapeutic Agent with Broad-Spectrum Antimicrobial Activity Against Drug-Resistant Bacteria. Angew. Chem. Int. Ed. 2020, 59, 3658–3664. [Google Scholar] [CrossRef]
- Zhang, L.; Zhang, L.; Deng, H.; Li, H.; Tang, W.; Guan, L.; Qiu, Y.; Donovan, M.J.; Chen, Z.; Tan, W. In vivo activation of pH-responsive oxidase-like graphitic nanozymes for selective killing of Helicobacter pylori. Nat. Commun. 2021, 12. [Google Scholar] [CrossRef]
- Zhang, W.; Ren, X.; Shi, S.; Li, M.; Liu, L.; Han, X.; Zhu, W.; Yue, T.; Sun, J.; Wang, J. Ionic silver-infused peroxidase-like metal-organic frameworks as versatile "antibiotic" for enhanced bacterial elimination. Nanoscale 2020, 12, 16330–16338. [Google Scholar] [CrossRef]
- Zhang, Y.; Li, D.; Tan, J.; Chang, Z.; Liu, X.; Ma, W.; Xu, Y. Near-Infrared Regulated Nanozymatic/Photothermal/Photodynamic Triple-Therapy for Combating Multidrug-Resistant Bacterial Infections via Oxygen-Vacancy Molybdenum Trioxide Nanodots. Small 2021, 17, 2005739. [Google Scholar] [CrossRef] [PubMed]
- Liu, Z.; Wang, F.; Ren, J.; Qu, X. A series of MOF/Ce-based nanozymes with dual enzyme-like activity disrupting biofilms and hindering recolonization of bacteria. Biomaterials 2019, 208, 21–31. [Google Scholar] [CrossRef] [PubMed]
- Zhao, Y.; Li, H.; Wang, Y.; Wang, Y.; Huang, Z.; Su, H.; Liu, J. CeO2 Nanoparticle Transformation to Nanorods and Nanoflowers in Acids with Boosted Oxidative Catalytic Activity. ACS Appl. Nano Mater. 2021, 4, 2098–2107. [Google Scholar] [CrossRef]
- Filippi, A.; Liu, F.; Wilson, J.; Lelieveld, S.; Korschelt, K.; Wang, T.; Wang, Y.; Reich, T.; Poeschl, U.; Tremel, W.; et al. Antioxidant activity of cerium dioxide nanoparticles and nanorods in scavenging hydroxyl radicals. RSC Adv. 2019, 9, 11077–11081. [Google Scholar] [CrossRef] [Green Version]

Publisher’s Note: MDPI stays neutral with regard to jurisdictional claims in published maps and institutional affiliations. |
© 2021 by the authors. Licensee MDPI, Basel, Switzerland. This article is an open access article distributed under the terms and conditions of the Creative Commons Attribution (CC BY) license (https://creativecommons.org/licenses/by/4.0/).
Share and Cite
Zhu, W.; Wang, L.; Li, Q.; Jiao, L.; Yu, X.; Gao, X.; Qiu, H.; Zhang, Z.; Bing, W. Will the Bacteria Survive in the CeO2 Nanozyme-H2O2 System? Molecules 2021, 26, 3747. https://doi.org/10.3390/molecules26123747
Zhu W, Wang L, Li Q, Jiao L, Yu X, Gao X, Qiu H, Zhang Z, Bing W. Will the Bacteria Survive in the CeO2 Nanozyme-H2O2 System? Molecules. 2021; 26(12):3747. https://doi.org/10.3390/molecules26123747
Chicago/Turabian StyleZhu, Weisheng, Luyao Wang, Qisi Li, Lizhi Jiao, Xiaokan Yu, Xiangfan Gao, Hao Qiu, Zhijun Zhang, and Wei Bing. 2021. "Will the Bacteria Survive in the CeO2 Nanozyme-H2O2 System?" Molecules 26, no. 12: 3747. https://doi.org/10.3390/molecules26123747




